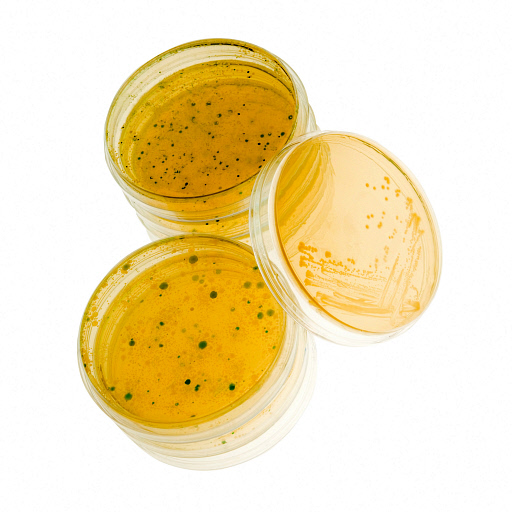

We asked author and journalist Marcus Chown, who is speaking at this month’s Lates, to share his favourite science facts.
I’ve just published a book about how the world of the 21st century works. It’s about everything from finance to thermodynamics, sex to special relativity, human evolution to holography. As I was writing it, I began to appreciate what an amazing world we live in – more incredible than anything we could possibly have invented – which is why I called my book What A Wonderful World. What better way to illustrate this than to list my Top 10 Bonkers Things About the World.
1. The crucial advantage humans had over Neanderthals was sewing
Human needles made from bone have been unearthed but never a Neanderthal needle. This has led to the speculation that the ability to sew baby clothes may have given human babies a crucial survival advantage during the cruel Ice Age winters.
2. You could fit the entire human race in the volume of a sugar cube

This is because atoms are 99.9999999999999% empty space. If you could squeeze all the empty space out of all the atoms in all the 7 billion people in the world, you could indeed fit them in the volume of a sugar cube.
3. Slime moulds have 13 sexes
No one knows why. But, then, nobody is sure why there is sex. The best bet, however, is that it evolved to outsmart parasites. Parents, by shuffling together their genes, continually create novel offspring to which parasites are not adapted.
4. You age more quickly on the top floor of a building than the ground floor
This is an effect of Einstein’s theory of gravity, which predicts that time flows more slowly in strong gravity. On the ground floor of a building, you are closer to the mass of the Earth so gravity is marginally stronger and time flows marginally more slowly (If you want to live longer – move to a bungalow!)
5. J. J. Thomson got the Nobel prize for showing that an electron is a particle. His son got it for showing that it isn’t
The ultimate building blocks of matter – atoms, electrons and so on – have a strange dual nature, behaving simultaneously like tiny, localised billiard balls and spread-out waves. The truth is they are neither particles nor waves but something for which we have no word in our vocabulary and no analogy in the familiar, everyday world.
6. You are 95% alien
That’s right. 95% of the cells in your body do not belong to you. They are microorganisms hitching a ride. Many are essential like the gut bacteria that help you digest your food. You get all the alien microorganism only after you are born – from your mother’s milk and the environment. You are born 100% human but die 95% alien!
7. Brains are so energy hungry most organisms on Earth do without them

The best illustration of this comes from the juvenile sea squirt. It swims through the ocean looking for a rock to cling to and make its home. When it finds one, it no longer needs its brain so it… eats it!
8. Babies are powered by rocket fuel

Rockets combine liquid oxygen with liquid hydrogen to make water. This liberates just about the most energy, pound for pound, of any common chemical reaction. Babies – and in fact all of us – do the same. We combine oxygen from the air with hydrogen stripped from our food. The energy liberated drives all the biological processes in our bodies.
9. There was no improvement in the design of stone hand axes for 1.4 million years

Palaeoanthropologists call it the ‘1.4 million years of boredom’. It could be of course that our ancestors made tools from wood, which decayed, or from bone, which are impossible to distinguish from natural bones. And, just because tools did not change, does not mean nothing was happening. All kinds of things that left no record may have been going on such as the taming of fire and the invention of language.
10. 98% of the Universe is invisible

Only 4 per cent of the mass of the Universe is made of atoms – the kind of stuff, you, me, the stars and planets are made of – and we have seen only half of that with our telescopes. 23% of the Universe is invisible, or “dark”, matter, whose existence we know of because it tugs with its gravity on the visible stuff. And 73% is dark energy, which is invisible, fills all of space and has repulsive gravity which is speeding up the expansion of the Universe. If you can find out what the dark matter or dark energy is, there is a Nobel prize waiting for you!
Find out more at this month’s Lates or in Marcus Chown’s book What A Wonderful World: One man’s attempt to explain the big stuff (Faber & Faber).
